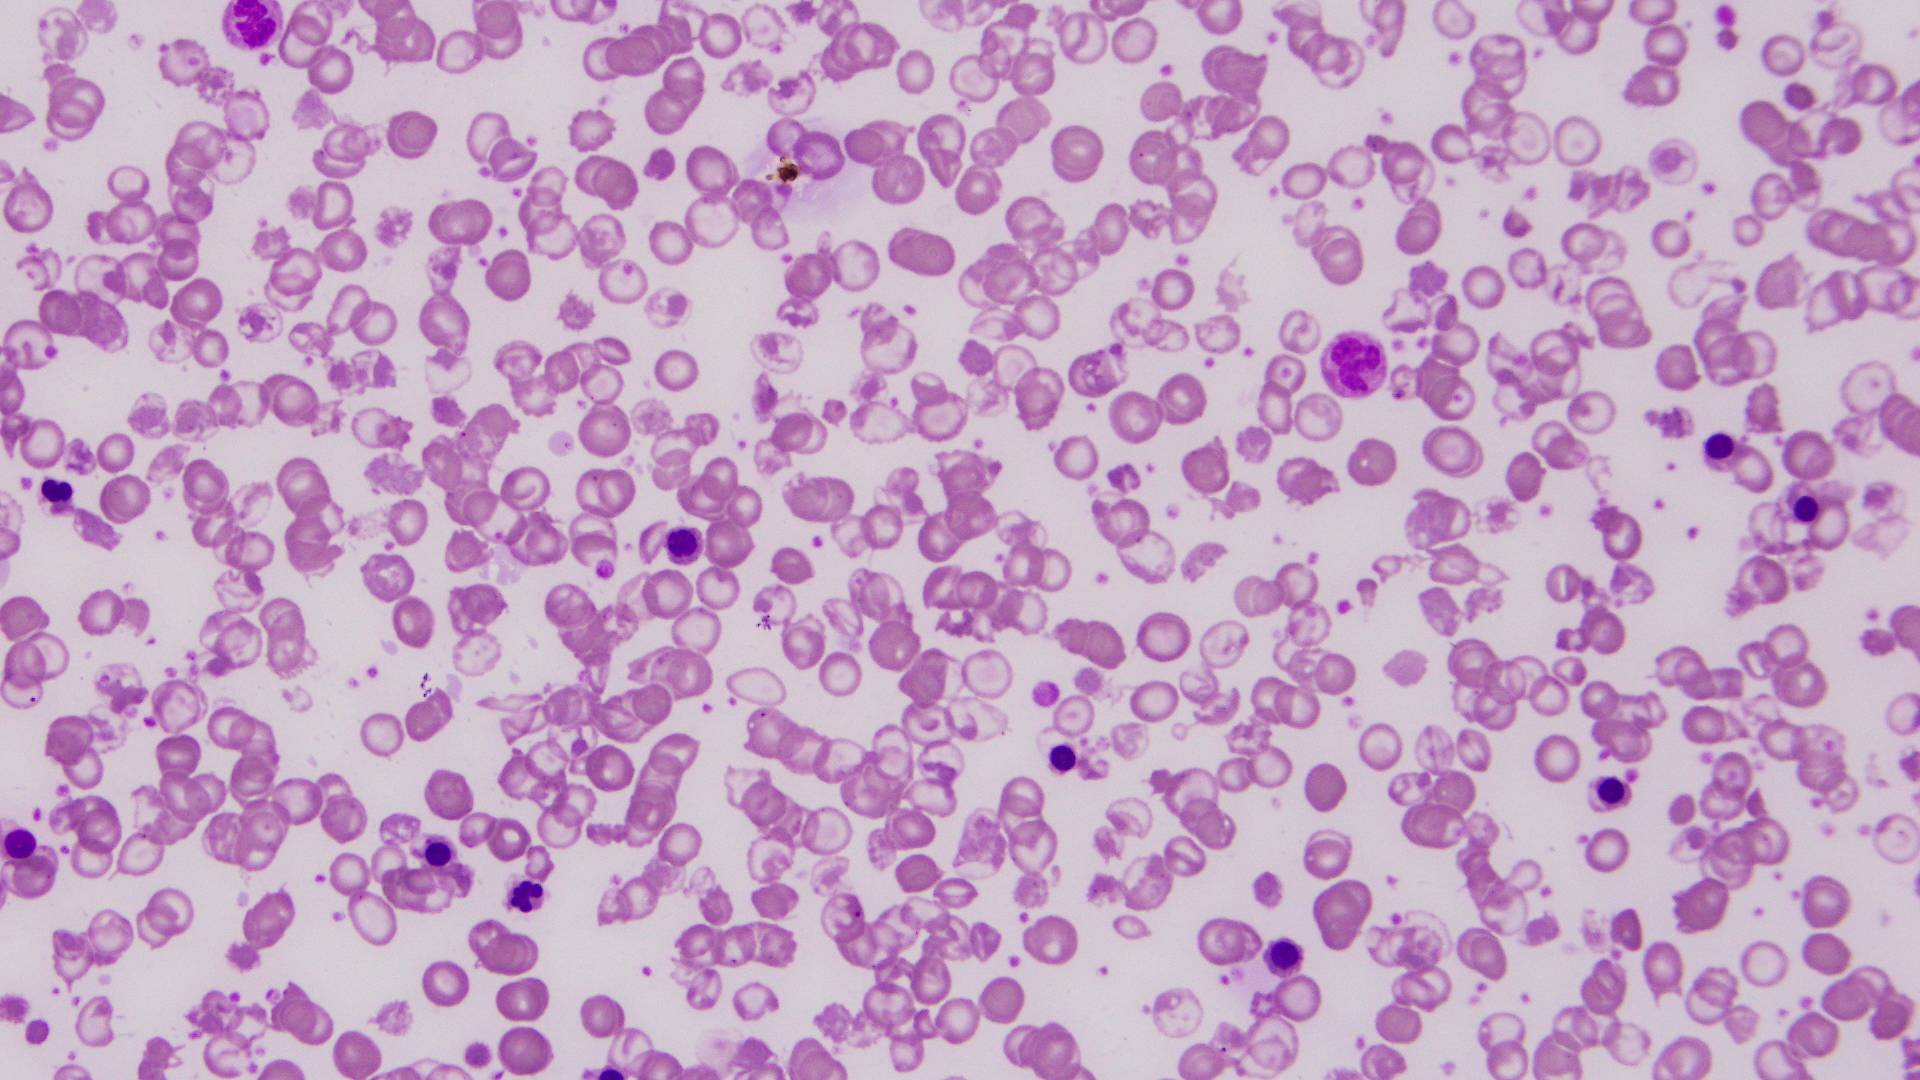
Thalassemia là bệnh di truyền lặn trên nhiễm sắc thể thường, đặc trưng bởi rối loạn tổng hợp hemoglobin

Các bệnh lý di truyền ngày càng được chú trọng trong y học hiện đại do ảnh hưởng lâu dài đến sức khỏe cá nhân và cộng đồng. Phát hiện sớm người mang gen bệnh sẽ giúp phòng ngừa biến chứng nặng cũng như giảm gánh nặng y tế cho gia đình và xã hội một cách hiệu quả.
Vì sao cần làm xét nghiệm Thalassemia?
Thalassemia là bệnh di truyền lặn trên nhiễm sắc thể thường, đặc trưng bởi rối loạn tổng hợp hemoglobin. Trong bệnh lý này, quá trình sản xuất các chuỗi globin bị suy giảm một phần hoặc hoàn toàn, dẫn đến mất cân đối trong cấu trúc hemoglobin và gây thiếu máu mạn tính. Xét nghiệm Thalassemia đóng vai trò then chốt trong phát hiện người mang gen bệnh và phòng ngừa sinh con mắc thể nặng. Đây là bệnh có thể phòng ngừa hiệu quả nếu được tầm soát sớm, đặc biệt ở các cặp đôi chuẩn bị kết hôn hoặc mang thai.
Thực tế cho thấy, chi phí dành cho việc phòng ngừa bệnh thấp hơn rất nhiều so với chi phí điều trị lâu dài cho bệnh nhân thể nặng. Trẻ mắc Thalassemia nặng cần truyền máu suốt đời và đối mặt với nguy cơ quá tải sắt, suy tim, suy gan và nhiều biến chứng khác. Ngược lại, người mang gen bệnh hoặc thể nhẹ vẫn có thể sống gần như bình thường nếu được theo dõi đúng cách.
Để phòng bệnh hiệu quả cần xác định chính xác loại đột biến gen cũng như đặc điểm lâm sàng liên quan. Điều này giúp bác sĩ đưa ra tư vấn sinh sản phù hợp góp phần giảm dần tỷ lệ di truyền gen bệnh trong cộng đồng.
Xét nghiệm gen Thalassemia mất bao lâu? Khi nào có kết quả xét nghiệm?
Xét nghiệm Thalassemia thường được thực hiện bằng cách lấy mẫu máu tĩnh mạch. Mẫu máu sau đó được đưa đến phòng xét nghiệm để phân tích các chỉ số huyết học và gen di truyền liên quan. Thông thường, thời gian phân tích mẫu kéo dài khoảng 2 - 3 ngày làm việc. Đây cũng là khoảng thời gian phổ biến được nhiều cơ sở y tế áp dụng khi trả lời câu hỏi xét nghiệm gen thalassemia bao lâu có kết quả. Trong một số trường hợp đặc biệt như cần phân tích chuyên sâu hoặc số lượng mẫu lớn thì thời gian trả kết quả có thể kéo dài hơn.
Kết quả xét nghiệm Thalassemia sẽ cho biết người được xét nghiệm có mang gen bệnh hay không, thuộc thể nào và nguy cơ di truyền cho con ra sao. Dựa trên kết quả này, bác sĩ sẽ tư vấn hướng theo dõi, điều trị hoặc các biện pháp sinh sản phù hợp trong tương lai.
Các xét nghiệm giúp chẩn đoán bệnh Thalassemia
Để chẩn đoán đầy đủ bệnh tan máu bẩm sinh, bác sĩ thường chỉ định kết hợp nhiều xét nghiệm khác nhau. Mỗi xét nghiệm có vai trò riêng trong việc sàng lọc và xác định bệnh.
Xét nghiệm tổng phân tích tế bào máu
Đây là xét nghiệm cơ bản và thường được thực hiện đầu tiên. Kết quả giúp đánh giá số lượng hồng cầu hemoglobin và các chỉ số liên quan. Những bất thường như thiếu máu hồng cầu nhỏ nhược sắc có thể gợi ý nguy cơ Thalassemia.

Xét nghiệm huyết đồ
Xét nghiệm huyết đồ giúp đánh giá chi tiết hình thái và chất lượng hồng cầu thông qua các chỉ số như MCV, MCH và MCHC. Kết quả này hỗ trợ phân biệt thiếu máu do Thalassemia với thiếu máu thiếu sắt hoặc các nguyên nhân khác. Ngoài ra, xét nghiệm còn phát hiện các hình dạng hồng cầu bất thường.
Điện di huyết sắc tố
Điện di huyết sắc tố là xét nghiệm quan trọng nhằm xác định các loại hemoglobin trong máu. Phương pháp này giúp định hướng chẩn đoán Thalassemia thể alpha, beta và theo dõi hiệu quả điều trị. Đây cũng là xét nghiệm cần thiết trong tư vấn di truyền cho các cặp vợ chồng mang gen bệnh.
Xét nghiệm tủy đồ
Xét nghiệm tủy đồ được chỉ định trong một số trường hợp nghi ngờ bệnh tan máu bẩm sinh mức độ nặng. Kết quả cho thấy sự tăng sinh mạnh của dòng hồng cầu trong tủy xương, phản ánh cơ chế bù trừ của cơ thể khi thiếu máu kéo dài.
Phân tích sinh học phân tử hoặc xét nghiệm DNA
Xét nghiệm DNA giúp phát hiện chính xác các đột biến gen gây Thalassemia. Đây là tiêu chuẩn vàng trong chẩn đoán xác định người mang gen bệnh. Kết quả xét nghiệm gen có giá trị lâu dài và không thay đổi theo thời gian.
Ngoài ra, bác sĩ có thể chỉ định thêm các xét nghiệm sinh hóa như bilirubin, ferritin để đánh giá mức độ tan máu và tình trạng quá tải sắt nhằm hỗ trợ điều trị.

Chi phí thực hiện xét nghiệm Thalassemia
Các xét nghiệm sàng lọc Thalassemia thường có chi phí không quá cao và được thực hiện nhanh chóng. Chi phí cụ thể phụ thuộc vào loại xét nghiệm, số lượng gen phân tích và cơ sở y tế thực hiện.
Việc chủ động xét nghiệm giúp hạn chế nguy cơ sinh con mắc bệnh thể nặng, từ đó giảm gánh nặng kinh tế, tinh thần cho gia đình và xã hội. Vì vậy, các cặp đôi trước khi kết hôn hoặc có kế hoạch sinh con nên thực hiện tầm soát di truyền sớm.
Cần làm gì khi được chẩn đoán mắc Thalassemia?
Hướng xử lý khi được chẩn đoán Thalassemia phụ thuộc vào thể bệnh và mức độ thiếu máu. Người mang gen bệnh hoặc thể nhẹ thường không cần điều trị đặc hiệu mà chỉ theo dõi định kỳ và duy trì lối sống lành mạnh.
Với các thể trung bình và nặng, người bệnh có thể cần truyền máu định kỳ kết hợp thải sắt để phòng ngừa biến chứng quá tải sắt. Trong một số trường hợp lách to gây thiếu máu nặng, bác sĩ có thể cân nhắc phẫu thuật cắt lách. Các phương pháp điều trị mới như liệu pháp gen cũng đang được nghiên cứu và ứng dụng dần.
Đối với các cặp vợ chồng cùng mang gen bệnh, bác sĩ thường tư vấn thụ tinh ống nghiệm kết hợp sàng lọc phôi nhằm lựa chọn phôi không mang gen Thalassemia trước khi chuyển vào tử cung. Giải pháp này giúp sinh ra thế hệ khỏe mạnh và hạn chế di truyền bệnh trong cộng đồng.

Tóm lại, xét nghiệm gen thalassemia mất bao lâu là vấn đề quan trọng cần được tìm hiểu rõ để giúp người bệnh chủ động trong theo dõi và kế hoạch sinh sản. Thalassemia là bệnh di truyền nghiêm trọng nhưng hoàn toàn có thể phòng ngừa nếu được tầm soát sớm và quản lý đúng cách. Việc thực hiện xét nghiệm và tuân thủ tư vấn y tế là chìa khóa bảo vệ sức khỏe cá nhân và tương lai của thế hệ sau.
:format(webp)/470051785_8767135473405056_691967411107495592_n_6b2bbff755.png)
:format(webp)/467434554_545745841560409_1066418224364723785_n_560a494f9c.png)
/xet_nghiem_erythropoietin_la_gi_1_9a43964313.png)
/cach_hieu_dinh_luong_glucose_mau_va_cham_soc_suc_khoe_duong_huyet_4_4a31919395.png)
/benh_a_z_gaucher_1_1cdb894e31.jpg)
/xet_nghiem_ung_thu_vom_hong_gom_nhung_gi_va_khi_nao_can_thuc_hien_1_3758cd2011.png)
/men_gan_cao_1500_co_nguy_hiem_khong_nguyen_nhan_gay_tang_men_gan_dot_ngot_4_f869e7f029.png)